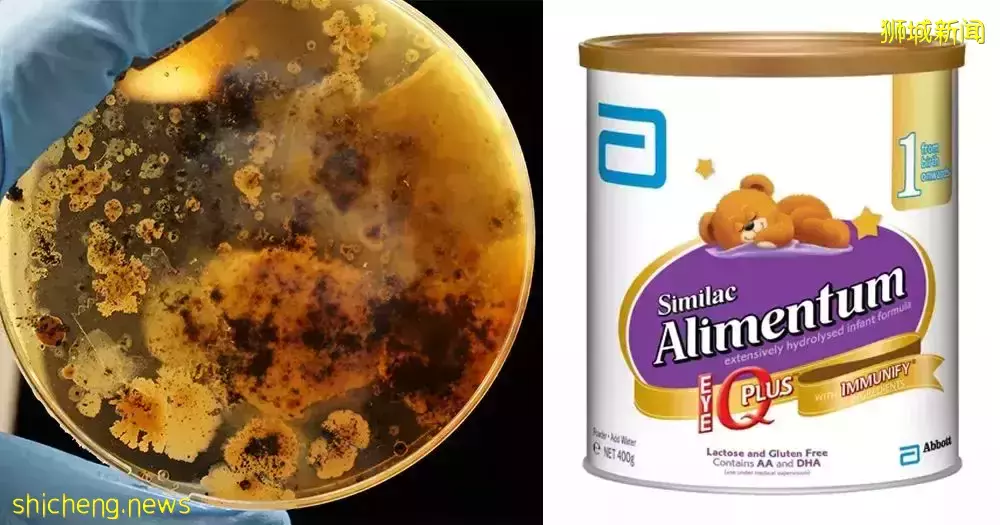
紧急召回！这款奶粉导致孩子发烧、腹泻，你在新加坡买了吗

紧急召回!这款奶粉导致孩子发烧、腹泻,你在新加坡买了吗
家有奶粉娃的妈妈们注意了!新加坡食品局(SFA)宣布召回部分批次的美国雅培营养婴儿配方奶粉!
(图源:Mothership)
SFA表示,召回的原因,是因为雅培营养(Abbott Nutrition)婴儿配方奶粉可能含有阪崎肠杆菌和新港沙门氏菌。此次召回是由美国食品和药物管理局发布的通知引发的。
迄今为止,美国机构已收到4起相关的消费者投诉,这些投诉与2021年9月至今年1月期间Abbott Nutrition位于密歇根州出厂的产品有关。

因此SFA已指示Abbott Laboratories (S) Pte Ltd在新加坡召回涉及的奶粉批次。
被召回的奶粉批次信息
代码的前两位数字是“22”到“37”;
容器上的代码包含“K8”、“SH”或“Z2”
保质期到2022年4月1日或之后,且源自美国。

(示意图)
细菌感染的症状
阪崎肠杆菌和新港沙门氏菌是致病菌。
虽然阪崎克罗诺杆菌感染通常很少见,但会导致脑膜炎或败血症,症状包括发烧、喂养不良或嗜睡。

而我们比较熟悉的沙门氏菌可引起胃肠道疾病,出现发烧、腹部绞痛和腹泻等症状。
SFA表示,担心的父母或看护人应停止使用该产品。
我该怎么做?
如果你家有此批次的奶粉,应该立即停用,并联系商家。如果宝宝已经食用了,并且感到不适,应该立刻寻求医疗帮助。
如果不确定自己购买的是不是被召回的批次,也可以联系商家进行查询。
评论